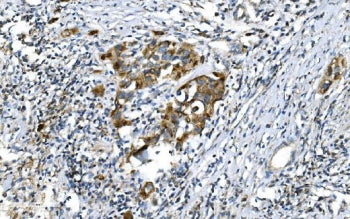

NSJ Bioreagents
SKU:RQ5810
DNM1L Antibody / Dynamin-1-like protein / DRP1
DNM1L Antibody / Dynamin-1-like protein / DRP1
Couldn't load pickup availability
Dynamin-1-like protein is a GTPase that regulates mitochondrial fission. In humans, dynamin-1-like protein, which is typically referred to as dynamin-related protein 1 (Drp1), is encoded by the DNM1L gene. The encoded protein mediates mitochondrial and peroxisomal division, and is involved in developmentally regulated apoptosis and programmed necrosis. Dysfunction of this gene is implicated in several neurological disorders, including Alzheimer's disease. Mutations in this gene are associated with the autosomal dominant disorder, encephalopathy, lethal, due to defective mitochondrial and peroxisomal fission (EMPF). Alternative splicing results in multiple transcript variants encoding different isoforms.
Share